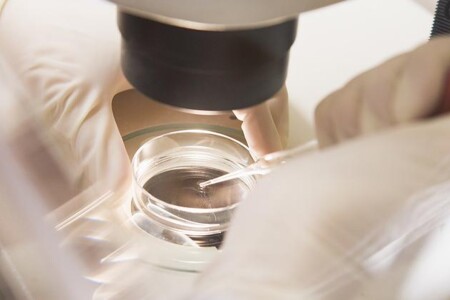
Léčba ženské neplodnosti

Dehydratace je nedostatek tekutin v těle. Ohrožuje především děti a staré lidi.

Trápí vás potíže s neplodností? Náš tým lékařů sepsal kompletní přehled informací o hlavních příznacích a příčinách neplodnosti. Zaměřili jsme se na nejčastější komplikace jako je imunologická neplodnost či imunitní poruchy těhotenství a neplodnost u mužů nebo neplodnost u žen. A léčebné metody neplodnosti, kam patří léčba mužské neplodnosti, léčba ženské neplodnosti nebo asistovaná reprodukce.
Pokud byste přece jen nenašli pomoc, podívejte se do diskuze nebo se zeptejte v odborné poradně.
Asistovaná reprodukce je metoda, která pomáhá s početím párům, kterým se nedaří počít přirozenou cestou. Existuje několik způsobů, jak pomoci neplodným párům s reprodukcí. Těmto metodám se podrobně věnujeme v jiném článku. Koho se tedy metody asistované reprodukce týkají?
Nitroděložní tělísko neboli IUD (intrauterine contraception device) je formou antikoncepce, kterou zavádí gynekolog přímo dovnitř dělohy. Její velkou výhodou je, že se od ženy nevyžaduje žádná další péče.
Spermatogeneze je proces, při kterém vznikají spermie ve varleti za současné podpory speciálních buněk a za účasti hormonu testosteronu. Proces spermatogeneze vyžaduje určité teplotní podmínky, okolo32°C, aby mohl správně fungovat. Proto může přehřívání varlat, například častými teplými koupelemi, vést až k narušení spermatogeneze a tím k neplodnosti.
Imunitní poruchy těhotenství tvoří zvláštní skupinu poruch, díky nimž může v krajním případě dojít až k potratu plodu. Mezi nejčastější příčiny patří tvorba protilátek proti spermiím v děložním hrdle nebo protilátek proti trofoblastu a tím neschopnost uhnízdění zárodku v děloze. Dalšími příčinami může potom být autoimunitní onemocnění matky nebo nekompatibilita v Rh faktoru.
Imunologická neplodnost vzniká poškozením nebo nefunkcí určitých přirozených bariér v těle muže nebo ženy. Tím může docházet k útoku imunitního systému proti spermiím nebo dokonce proti tkáním samotného vajíčka. Tato situace nastává například při poranění varlat nebo při nedostatečné tvorbě látky, která chrání spermie proti imunitnímu systému ženy. Na vině může být i autoimunitní onemocnění ženy, které bojuje proti vajíčku a způsobí např. potrat.
Neplodnost u žen může být způsobena z různých příčin, mezi které se řadí poruchy genetické a hormonální, nefunkční vaječníky, srůsty na vejcovodech či psychika ženy. Rozmnožování je složitý a komplexní proces, jehož porucha je vážný a ne vždy objasněný problém. Avšak díky moderní medicíně jsou v dnešní době šance na těhotenství vyšší, než kdy dříve.
Neplodnost u mužů může být způsobena na několika úrovních. Může jít o porušení funkce hormonů mozku, to může být způsobeno například užíváním anabolik. Další příčinou je porucha funkce tkáně ve varleti, kde dozrávají spermie. Ty pak nemusí být přítomny v ejakulátu, aniž by si toho pacient všiml. Další příčina neplodnosti u mužů může být způsobena poruchou erekce, ejakulace nebo ucpáním chámovodu, což je ve většině případů možné vyléčit.
Prevence neplodnosti je poměrně diskutované téma, jelikož více jak 15% párů má problémy s otěhotněním. V prevenci neplodnosti hraje celkově roli zdravý životní styl, omezení konzumace alkoholu, drog a cigaret, udržování přiměřené tělesné hmotnosti, pravidelné kontroly u lékaře a nezanedbávání infekčních onemocnění.
Neplodnost je jiné označení pro neschopnost počít dítě a je způsobená různými příčinami. V dnešní době je neplodnost velmi diskutované téma, jelikož se týká asi 15% párů. V České republice existuje asi 30 center zabývajících se neplodností, tzv. centra asistované reprodukce. Jejich vlivem došlo ke snížení neschopnosti párů počít vlastního potomka na 3-5%.
Bolesti v podbřišku mohou být projevem onemocnění orgánů, které jsou umístěné v této oblasti. U žen jsou často bolesti v podbříšku spjaty s jejich menstruačním cyklem. Dále mohou bolesti v podbříšku znamenat nejrůznější onemocnění trávicího nebo močového traktu. Bolesti v podbříšku nelze brát na lehkou váhu a vždy je lepší vyhledat lékařskou pomoc.
Zpoždění menstruace je nepříjemná odchylka v menstruačním cyklu, která může a nemusí souviset s nemocí. Mezi běžné a méně závažné příčiny nepravidelné menstruace patří stres, změna životního stylu a například také hubnutí. Zpožděná menstruace může být ale také výsledkem poruchy hormonálních hladin, poruchy v pohlavních orgánech a někdy také nádorovým onemocněním...
Krvácení mimo menstruaci může být příznakem onemocnění pohlavních orgánů, především dělohy, avšak může být také nežádoucím účinkem při užívání hormonální antikoncepce či různých léků. Jaké krvácení se může objevit a u jakých onemocnění je krvácení mimo menstruaci příznakem najdete v tomto článku.
Hysterektomie je chirurgický zákrok, při kterém se buď částečně nebo úplně odstraní děloha, společně s dalšími orgány, jako jsou vaječníky či vejcovody v případě zvýšeného rizika nádorového bujení. Hysterektomii se vždy snažíme vyhnout u žen, které ještě chtějí mít děti. Operace se nejčastěji provádí u žen ve věku mezi 45 a 55 lety; v tomto věku se onemocnění, která jsou důvodem pro hysterektomii, vyskytují nejčastěji.
Spermiogram je speciální vyšetření spermií pod mikroskopem, které umožňuje zjistit jejich kvalitu. Spermiogram se provádí, pokud má pár problém s početím nebo pokud se muž sám rozhodne darovat sperma. Na spermiogramu se hodnotí kvalita, kvantita spermií, jejich rychlost, směr pohybu i přítomnost protilátek ve spermatu a jeho pH. Na základě výsledků spermiogramu může lékař doporučit následný postup.
In vitro fertilizace neboli IVF je jedna z metod asistované reprodukce. In vitro fertilizace je oplodnění vajíčka spermií mimo tělo pacientky, v laboratoři. Používá se při neprůchodnosti obou vejcovodů nebo při rizicích spojených s dědičnými onemocněními, vyjímkou pak není ani dárcovství vajíčka dárkyní. Při IVF je odebráno od muže sperma a pacientce nebo dárkyni vajíčka a nechají se oplodnit. Do dělohy pacientky je poté vloženo již oplozené vajíčko. IVF je poměrně účinná metoda, nese s sebou však určitá rizika, především vlivem hormonální stimulace pacientek.
Dárcovství embryií je metodou asistované reprodukce, která se používá u párů, kde jsou neplodní oba partneři. Pár si vybírá mezi hledáním dárce a dárkyně nebo použitím embrya z kryobanky, tzn. zmraženého embrya vzniklého při metodách asistované reprodukce jiného páru. Procento přežití embryí po rozmražení však není stoprocentní. Dárcovství embryí je anonymní a klienti si vybírají embrya podle charakteristik dárkyně vajíčka a dárce spermatu, tak aby jim byli co nejvíce podobní.
Dárcovství vajíček je jednou z možností léčby neplodnosti žen. Dárcovství vajíček je metodou, při které mladá zdravá žena poskytne vajíčko neplodné ženě. Darované vajíčko se nechá oplodnit spermiemi partnera a takto vzniklé embryo se vloží do dělohy ženy. Dárcovství vajíček je komplikovaný a finančně náročný proces spjatý s určitými riziky. V České republice je dárcovství vajíček bezplatné a přísně anonymní, kvůli ochraně budoucího dítěte.
Dárcovství spermií je metoda, která umožňuje početí neplodným párům, kde příčinou neplodnosti páru je neschopnost muže tvořit živé spermie. Principem dárcovství spermií je oplodnění vajíčka spermiemi cizího muže, který je přísně anonymní. V dnešní době rozvoje metod asistované reprodukce se od využití dárcovství spermií lehce upouští, je dávána přednost oplodnění spermiemi partnera.
Preimplantační genetická diagnostika se provádí při metodách asistované reprodukce, kdy je žádané zkontrolovat genetickou výbavu zárodku ještě před vpravením do těla pacientky. Preimplantační diagnostiku také podstupují všechny darované vzorky (spermie i vajíčka). Dále je pak genetická diagnostika doporučována párům, které již genetické onemocnění mají nebo je potvrzen jeho výskyt v rodině.Vhodně provedenou preimplantační diagnostikou je tak možné předcházet určitým genetickým dědičným onemocněním.
Kryokonzervace je metoda, která umožňuje uchovávat vajíčka, spermie, ale i embrya. Před kryokonzervací jsou všechny vzorky pečlivě testovány na choroby jako je HIV nebo žloutenka, poté jsou zamrazeny na -195°C. Zamrazování může probíhat buď postupným snížováním teploty nebo přímým zmrazením, před každou metodou je však nutné odvodnění.Účinnost zmrazených vzorků je poměrně nízká, pohybuje se kolem 18%, dosud není však známý důvod, proč tomu tak je.
Intracytoplazmatická injekce spermie je jednou z metod asistované reprodukce. Intracytoplazmatická injekce spermie neboli ICSI se využívá především při poruchách pohyblivosti spermií. Jedná se o metodu, kdy je vajíčko oplozeno mimo tělo pacientky tak, že je do něj pod mikroskopem vpravena vybraná kvalitní spermie.Takto oplozené vajíčko je dále vloženo do dělohy pacientky.V současné době,kdy mužů se špatnou pohyblivostí spermií přibývá, se intracytoplazmatická injekce spermie stala velkým přínosem.
Intrauterinní inseminace neboli IUI je jednou z metod asistované reprodukce. Intrauterinní inseminace se používá u párů, které nemohou počít přirozenou cestou a to především z důvodu špatné pohyblivosti spermií nebo při imunitní reakci ženy na partnerovy spermie. Intauterinní inseminace je proces, kdy jsou spermie dopraveny přímo do dělohy, kde potom může snáze dojít k oplodnění. Přestože tato metoda je poměrně šetrná, není zdaleka použitelná u všech příčin neplodnosti.
Centra asistované reprodukce jsou specializovaná centra zabývající se poruchami plodnosti a poskytující řešení pro většinu párů pokoušejících se o početí. Na začátku bývají oba dva partneři v centru asistované reprodukce podrobeni důkladným vyšetřením, na jejichž základě je jim doporučena alternativní metoda početí. Při úspěchu a vydařeném oplodnění je pár dále sledován v průběhu celého těhotenství.
Asistovaná reprodukce je moderní možností léčby neplodnosti. Mezi dnes již klasické a běžně používané metody patří fertilizace in vitro neboli oplodnění ve zkumavce, nitroděložní inseminace nebo intracytoplazmatická injekce, která pomůže, pokud má spermie problém proniknout do vajíčka. Nově se používají metody, které umožňují odebrání spermií přímo z varlete muže a nazývají se MESA a TESE.
Léčba imunologické neplodnosti je proces, při kterém se lékaři snaží, aby tělo ženy neodmítalo spermie partnera, nebo buňky zárodku a zárodečných obalů. Další situací, kdy je nutná léčba imunologické neplodnosti, je narušení imunologické bariéry kolem varlat. Tím tělo muže napadá vlastní spermie. Tyto situace se v dnešní době léčí především podáváním imunosupresiv nebo metodami asistované reprodukce.
Léčba ženské neplodnosti přímo závisí na její příčině. Neplodnost způsobená nerovnováhou hormonů lze řešit podáváním příslušných léků, které navodí pravidelnou ovulaci. Srůsty na vejcovodech, popřípadě cysty, se dají řešit chirurgicky. Pokud však předchozí léčby selhaly nebo nejsou možné, užívají se metody asistované reprodukce, mezi které patří oplodnění in vitro, intracytoplazmatická injekce a nitroděložní inseminace.
Léčba mužské neplodnosti závisí především na příčině, která neplodnost způsobuje. Na vině může být například varikokéla či ucpání chámovodu, které se dají řešit chirurgicky. Naopak např. imunitní příčina se řeší podáním imunosupresiv. Řadu dalších příčin lze řešit metodami asistované reprodukce, mezi které patří oplodnění in vitro („ve zkumavce“) , nitroděložní inseminace nebo intracytoplazmatická injekce.
Oplození ve zkumavce, jinak také známé jako IVF, je jednou z metod asistované reprodukce, která se používá při léčbě neplodnosti. Metodou IVF se konkrétně řeší problém neprůchodnosti vejcovodů, nepřítomnosti ovulace, nízké či nedostatečné kvality spermií muže, neplodnost způsobenou hormonálními poruchami, imunologické faktory či faktory genetické. Jak se metoda IVF provádí a jaká případná rizika může mít, se dozvíte v tomto článku.